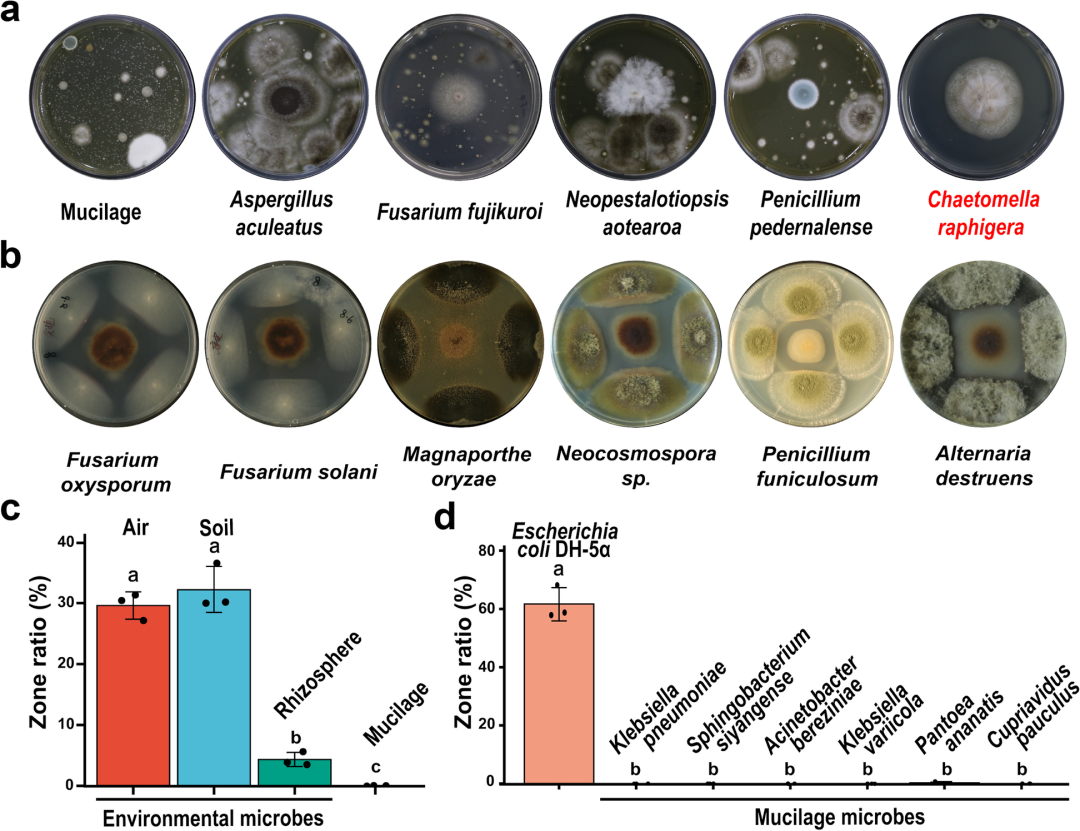

植物气生根-黏液微生境具有固氮生物学功能及其稳态维持机制
Microbiota-mediated nitrogen fixation and microhabitat homeostasis in aerial root-mucilage

Article,2023-4-21,Microbiome,[IF 16.837]
DOI:.1186/s40168-023-01525-x
原文链接:https://microbiomejournal.biomedcentral.com/articles/10.1186/s40168-023-01525-x
第一作者:庞志强、毛新雨、周绍群
通讯作者:胡凌飞、徐鹏
主要单位:中科院版纳植物园、农科院基因组所、浙江大学
- 导读 -
中国科学院西双版纳热带植物园在植物气生根黏液微生境的生物学功能及其稳态维持机制方面取得新进展。该研究发现了一种具有气生根大量分泌黏液的藤蔓植物蔓性野牡丹,通过代谢组测定与微生物组测序发现气生根黏液与地下根际存在不同的化合物组成和微生物群落,基于基因组、转录组、微生物组及氮标记实验、控制实验等多组学研究技术与方法,首次系统阐明了双子叶植物的气生根黏液具有固氮的生物学功能并扩展了传统定义的“根际”术语。研究人员还在黏液中分离培养了具有广谱抗性的“保卫”真菌,并揭示了其维持微生物稳态的潜在机制。有助于加深对根系生物学功能与微生境稳态维持的见解,相关研究成果于2023年4月发表在《Microbiome》上。
- 研究背景 -
气生根作为特殊的根系类型与变态器官在植物适应特殊生境等方面扮演着重要作用,如可以促进淹水植物的气体交换、为攀援藤蔓等植物提供额外的机械支持。而气生根上附着的大量黏液则被认为能够维持湿润界面并根尖细胞提供润滑和保护作用。微生物组宿主植物养分利用、胁迫耐受性、宿主健康和适应性等方面发挥着重要作用。过去十年的微生物组研究揭示了与植物根际相关的多种微生物群落的重要功能,并激发了对气生根黏液中生化组成和微生物多样性的类似研究。在微生物组中能够生物固氮并直接促进宿主植物氮供应的固氮微生物类群引起了科研人员的广泛关注。迄今为止,除了地下根/根际生态位的固氮菌研究以外,植物根茎、木质部和气生根等特殊生态位的微生物促进宿主固氮的功能也逐渐被揭示。最近,一项开创性研究发现墨西哥玉米的气生根分泌大量富含碳水化合物的黏液及栖息于其中的固氮菌能贡献宿主植物29%-82%的生物固氮量(Van Deynze et al,2018,PLOS Biology)。对气生根黏液的微生物测序分析表明,其中富集多数固氮的细菌属,如伯克霍尔德菌Burkholderia、草螺菌Herbaspirillum和固氮螺菌Azospirillumin,这表明气生根黏液-微生物系统在满足植物氮需求方面发挥着重要作用。虽然气生根黏液分泌和固氮的潜在机制尚不清楚,但富含碳水化合物的黏液被认为是介导玉米-重氮菌群相互作用的重要区域和特殊生态位。更有趣的是,这个营养丰富的特殊生态位富集的是重要和具有功能的固氮微生物,而不是病原体和其他的环境微生物,这表明微环境的背后存在微生物功能的稳态维持。然而,这一过程的基本机制仍然未知。
因此,研究者利用最新发现的具有大量气生根黏液的藤蔓植物蔓性野牡丹(Heterotis rotundifolia)为研究对象,通过其气生根-黏液这一特殊的生物学现象,旨在回答以下两个科学问题:(1)双子叶植物气生根-黏液微环境的生物学功能及其潜在机制;(2)作为一种可能富含多糖等大量碳水化合物的“自然介质”,黏液生境是如何在变化的空气环境中维持其功能和稳态的?研究者通过微生物功能验证及氮标记实验发现蔓性野牡丹气生根黏液富含丰富的固氮菌,其中的微生物群落能够固定大气中的氮以支持植物生长。另外,研究者进一步鉴定了黏液中的一种关键的“友好”真菌F-XTBG8,它具有广谱的抗菌活性但却选择性地允许固氮菌的生长。
- 结果 -
1.气生根黏液与地下根系分泌物存在差异且富含大量碳水化合物
蔓性野牡丹植株匍匐生长时可以超过2 m并在茎节处形成气生根,这些产生黏液的气生根的长度从几乎肉眼可见到16 cm不等。研究者通过收集这些样本进行广泛靶向代谢组的测定,比较气生根黏液(Aerial Root Mucilage,以下简称ARM或黏液)和地下根系分泌物(Underground Root Exudates,以下简称URE或根系分泌物)的代谢物和化学组成(图1),主成分分析结果表明,黏液和根系分泌物样品的代谢谱有明显的区别,在两个样本中检测到1033个注释的代谢物中发现有531个存在显著差异(P=0.01)。地下根系分泌物中脂类和生物碱等次生代谢产物的相对含量较高,而气生根黏液中氨基酸衍生物、核苷酸衍生物、类黄酮和碳水化合物等初级代谢产物含量较高(图1d),研究者推测这与气生根黏液具有类似的粘性特性是一致的。研究者进一步针对两者的碳水化合物多糖物质进行靶向测定证实,黏液中含有丰富的葡萄糖、果糖和蔗糖,而地下根系分泌物中上述单糖和多糖含量较低(检测不到或含量低于0.01mg·g-1,图1e)。黏液中这类多糖的含量比地下根系分泌物高于近百倍,上述结果都表明黏液中富含丰富的碳水化合物,可能是个植物源天然的“培养基”。

图1 气生根粘液(ARM)和地下根系分泌物(URE)的代谢物含量差异
2. 气生根黏液中富集大量的固氮微生物类群
气生根黏液和地下根系分泌物的具有不同的生物化学组成,并且气生根黏液含有大量碳水化合物糖分等,这暗示它们可能提供了不同的营养物和形成了不同的生态位,“居住”喂养着不同的微生物群落。为了验证这一假设,研究者在中国科学院西双版纳热带植物园的5个蔓性野牡丹的分布地分别收集了气生根黏液、地下根际和空白环境土壤样本3个不同生态位的样品,并通过16S rRNA和ITS基因测序分析了样本的原核和真核微生物群落。基于Bray-Curtis指标的PCoA分析显示,气生根黏液的细菌和真菌组成与地下根际和土壤显著不同(P=0.001,图2)。值得注意的是,气生根黏液的原核生物alpha多样性显著低于地下根际和空白土壤(P=0.001),以上结果暗示气生根黏液中可能存在特殊的细菌群落。对于真菌群落来说,气生根黏液中的alpha多样性显著低于土壤。在气生根黏液和地下根际土壤之间共鉴定了233个差异富集的细菌属和65个真菌属(Wilcoxon秩和检验,P<0.05)。具体来说,气生根黏液中伯克霍尔德氏菌-卡巴拉氏菌-拟伯克霍尔德氏菌属(Burkholderia-Caballeronia-Paraburkholderia,BCP)、草螺杆菌属(Herbaspirllum)和新鞘氨醇杆菌属(Novosphingobium)在黏液中高度富集(图2)。前期已有很多研究表明,气生根黏液丰度最高的细菌属,BCP属组合和草螺杆菌属中包含许多固氮菌并已被广泛用作植物相关固氮微生物研究的模式菌株和系统。以上结果暗示着气生根黏液这一特殊的生态位中存在特殊的微生物组成和功能。

图2 气生根黏液(Mucilage)、地下根际(Rhizosphere)和土壤(Soil)的细菌多样性
为了证实上述假设和验证黏液中微生物的功能,研究者广泛分离培养并获得的一些纯培养物被鉴定为克雷伯氏菌属(Klebsiella)、鞘氨醇杆菌属(Sphingobacterium)、贪铜菌属(Cupriavidus)、不动杆菌属(Acinetobacter)和泛菌属(Pantoea)的细菌菌株,经过一些促生潜力的测试,发现这些菌株多数都能够在无氮培养基上生长和存在关键固氮基因nif H和其等位基因。为了进一步明确这些菌株具有固氮能力,使用氮标记稀释法对培养过程中的菌液进行标记培养。研究者发现这些菌株中的大多数在15N2标记的实验中显示了固氮活性(图3b)。这些数据使研究者进一步验证和推测,固氮可能是蔓性野牡丹气生根黏液相关的细菌群落的关键功能、气生根黏液可能具有固氮的生物学功能。

图3 气生根黏液和地下根际土壤中的可培养细菌分离及氮标记揭示其固氮能力
3. 气生根黏液能固定大气中的氮气并支持植物生长
研究者在上述结果中发现气生根黏液富集了大量具有固氮功能的细菌,暗示了固氮可能是蔓性野牡丹气生根黏液中细菌群落的关键功能和黏液可能具有固氮的生物学功能。为了进一步验证完整的气生根-黏液-微生物真的具有固氮生物学功能,研究者对植株进行了15N标记的15N2气体富集实验(纯度≥99%),设置了两组处理和对照组别:第一组为明确气生根黏液是否具有固氮功能设计的未标记的空白对照(14N2)及置换5%、10%和20%(V·V)标记处理组,第二组为量化气生根-黏液系统对固氮的贡献量设置的:有气生根及黏液、仅有气生根无黏液和无气生根(黏液)3种类型的植株,经过标记处理72 h后收集不同组织测定15N相对丰度(图4)。同位素质谱检测发现气生根黏液的植株在标记气体组与空白组相比存在明显差异(P=0.01),且随着标记气体体积增加的同时,在植株不同组织中检测到的15N标记丰度随之增加,暗示着氮气标记成功进入植物组织内。在所有的标记组中当置换20%的15N2标记气体时植株体内15N丰度变化最为明显,且具有气生根及黏液的植株在所有组织中的15N相对丰度显著高于仅有气生根无黏液或无气生根及黏液的植株。因此研究者进一步对20%标记氮气处理下的实验组别进行分析,在不同的植物气生根、幼叶、老叶、茎中都检测到15N显著的富集(P=0.01),且气生根部位高于其他组织,证明了黏液固定的氮素由气生根吸收后转移至其他植物部位。此外,不具气生根的植物组织均未显示出明显的15N变化,证明固氮的场所发生在根部而非叶片或茎中,而具有气生根-黏液的植株检测到的15N显著高于有气生根无黏液和完全无气生根的样品,表明气生根的黏液是发挥固氮功能的重要场所和生态位。同时有气生根无黏液的植株也显示出比无气生根更高的15N丰度,表明气生根内也可能存在内生固氮菌或因黏液未完全去除根系表面依然有固氮微生物存在。为了进一步明确气生根黏液固定的氮被植株所利用,研究者对植物源特有的代谢物进行15N同位素检测,提取未标记组和标记组植物组织中的叶绿素进行同位素质谱峰检测。因叶绿素易分解不稳定,研究者在检测中转换为脱镁叶绿素A(Pheophytin A,分子式C55H74N4O5,分子量871.45 m/z)进行质谱分析,重点检测该物质N原子形成的同位素875.57 m/z质谱峰,与预期结果一致,只有标记的气生根-黏液植物才能检测到同位素质谱峰的响应,而不具有气生根和未标记的植株均未检出,证明气生根黏液固氮的氮素可以被植物所吸收、利用和参与代谢过程。
此外,为了量化气生根-黏液系统对于植物固氮量的贡献值,对野外条件下自然生长的植株15N丰度进行测定和进行室内外黏液去除实验以表征气生根-黏液系统的固氮量。首先,大气固氮对植物的贡献可以通过固氮植物和非固氮植物的15N自然丰度值(δ15N)来量化。自然状态下,土壤中的δ15N比空气中更丰富,因此,与参考的非固氮植物相比,固氮植物的δ15N水平将降低。研究者采集了产黏液的蔓性野牡丹和相邻生长的无气生根的植物样品。在两年的时间里,产生黏液的样品的叶和茎的δ15N都低于没有气生根的植物,表明气生根-黏液系统能够从大气氮中获得很大一部分氮并固定于植物组织中,根据δ15N计算得到蔓性野牡丹气生根-黏液系统贡献了来自大气的氮的百分比(%Ndfa)为37.04%-54.85%。这些结果支持研究者的假设,即完整的气生根-黏液-微生物区系可以促进植物对大气氮的吸收。以上结果,表明了气生根及其伴生黏液中的微生物在固氮和支持蔓性野牡丹生长方面起到了重要作用。

图4 气生根粘液标记组显示具有固氮功能且促进植物生长与代谢过程
以上结果支持了研究者的假设即完整的气生根-黏液-微生物系统可以直接固定大气中的氮气并被植物所吸收和利用。为了进一步证实气生根-黏液系统是否能够满足上述结论,研究者在温室和野外生长环境下的去除蔓性野牡丹气生根黏液(实验组)并比较了人工切除气生根的植物和完整生长的对照植株的生长情况。在气生根-黏液切除并连续观测4个月后(所有植物气生根未进入土壤),实验组的植物总氮含量比对照组有气生根-黏液的植物降低40%,地上部生物量降低10%,这表明气生根-黏液-微生物系统在氮固定和支持支持蔓性野牡丹植株生长方面发挥着重要作用(图5)。

图5 去除植物气生根-黏液系统后植株总氮、干重和茎长均显著降低
4. 气生根黏液微生境发生碳氮代谢交换的分子生物学证据
联合固氮等生物固氮形式往往需要产生宿主与微生物的双向碳氮代谢与交换,因此需要在分子层面验证生物固氮的双向交换过程,对于气生根-黏液这一特殊的生态位也需要明确宿主植物和固氮微生物在分子水平上“合作”印记。因此,为了研究这一过程,研究者对蔓性野牡丹的基因组和不同类型气生根的样本取样进行转录组测序。
研究者首先对蔓性野牡丹的基因组进行了三代+二代PacBio测序,共获得61.86 G PacBio CLR reads和20.1 G Hi-C reads数据,组装后获得了染色体水平的参考基因组,随后用RNA-seq数据进行转录本范围的基因表达分析。研究者首次测定了该物种的参考基因组,大小为171.44 Mb,与研究者之前用流式细胞术预估的基因组大小类似。组装后的基因组Contig N50长度为8.39 Mb,Scaffold N50长度为11.23 Mb。共注释了29574个基因和2434个非编码RNA,通过Benchmarking Universal Single-Copy Ortholog analysis (BUSCO5)评估达98%。超过96%的基因通过gene ontology (GO), Kyoto Encyclopedia of Genes and Genomes (KEGG), Swissprot, TrEMBL和Pfam数据库得到功能注释。
然后,研究者对有无黏液等不同类型的气生根和地下根样品提取RNA进行转录组测序获得RNA-seq数据,对比分析不同样品的转录组范围内的基因表达异同(图6)。基于GO和KEGG注解的功能富集分析结果表明:光合作用和苯丙类代谢相关基因优先在气生根中表达,且这些基因表达差异在含具黏液的气生根和地下根中更为明显。稳定的植物-固氮微生物互作是建立在从宿主植物向固氮微生物大量的碳流动和氮反向流动(氮吸收),也就是碳氮交换过程的基础上。因此,研究者进一步检测了碳水化合物和氮转运蛋白基因在有无黏液的气生根和地下根系组织中的表达情况。结果发现在含黏液的气生根中,糖转运蛋白(如STP、SWEET、INV)、硝态氮和氨态氮转运蛋白和同化酶谷氨酰胺合成酶基因(如AMT、NRT和GS)的表达量显著高于不含黏液的气生根样品,表明当有黏液时碳氮交换与流动更活跃(图6)。与预期结果一致的是,在含黏液的气生根中高表达的硝态氮和氨态氮转运蛋白在地下根中也有高表达(NRT2.1除外),而碳水化合物转运蛋白在有黏液的气生根中表达量高于地下根系。以上结果均表明蔓性野牡丹的气生根黏液这一特殊的生态位具有固氮的生物功能及分子过程,蔓性野牡丹作为该属植物和产黏液的首个测序的双子叶植物,为进一步研究黏液代谢过程和固氮机制提供了分子基础。

图6 蔓性野牡丹转录组揭示了气生根黏液的生物学功能
5. 黏液微生境中的真菌Chaetomella raphigera具有维持微生物稳态的功能
气生根黏液中富含碳水化合物,为固氮菌细菌创造了一个理想的生态位和“天然培养基”,也代表着黏液有可能受到其他环境微生物包括环境中其他微生物和病原微生物的干扰。此前已经有丰富的文献介绍了植物分泌的特异性代谢物的在影响微生物群落结构方面的功能,即存在特殊的植物代谢物维持微生物的稳态与抵御病原菌的入侵,因此研究者也筛选评定了了黏液中最丰富的20种代谢物的抗菌能力,如没食子酸、精胺、表没食子酸儿茶素酸酯和邻苯二甲酸酐等。但遗憾的是,这些化合物大多数在平板中不同时具有抵御病原菌而允许固氮菌生长或实际实验的化合物浓度与黏液中实际的含量差别过大,也就是说暂未筛选到在生理浓度下显示明显抗生素功能的特定化合物(参考文章附图)。
因此研究者提出假设:黏液的微生物群落中的某些成员或特殊微生物可以选择性地允许固氮菌的生长但抑制“不受欢迎”的环境和病原微生物以维持黏液中固氮微生物的稳态。为了确定蔓性野牡丹气生根黏液微生物群落中潜在的“友好”或“警察保卫”微生物,研究者对黏液样品中分离到的56种真菌和细菌的单孢子/单菌落分离物通过在暴露于在空气中敞开培养基上培养,筛选它们的广谱抗菌活性。通过添加灭菌黏液的1% PDA培养基,研究者筛选到一种真菌培养物F-XTBG 8在暴露于空气中的5天后仍未明显被其他微生物生长和平板污染。通过ITS测序该菌被鉴定为Chaetomella raphigera)(图7)。随后的微生物拮抗实验表明,黏液中分离出的C. raphigera菌株可以抑制100多种常见的植物病原菌和环境中的真菌的生长,包括尖孢镰刀菌(Fusarium oxysporum)、腐皮镰刀菌(Fusarium solani)和稻瘟菌(Magnaporthe oryzae)等病原菌(图7)。
为了确定F-XTBG8与其他微生物之间的相互作用,研究者进一步将F-XTBG8及其代谢物与黏液菌株和其他环境微生物共同培养在模拟ARM微生境的培养基中。有趣的是,这种C. raphigera菌株的液体培养代谢物对空气和土壤细菌群落有明显的抑制作用,但在对蔓性野牡丹的地下根际微生物进行测试时,这种作用明显减弱,而在对黏液细菌进行测试时,这种作用完全消失,这可能是因为气生根在进入土壤后成为正常的地下根。此外,C. raphigera的液体培养物抑制了一种常见的细菌大肠杆菌(Escherichia coli DH-5α)的生长,但对从黏液中分离的6种固氮细菌菌株都没有抑制作用。对气生根-黏液样品进行两年的微生物扩增子测序,研究者发现该真菌属在黏液的相对丰度高于地下根际,其在土壤样品中的测序读数表明该真菌可能来自蔓性野牡丹生长的土壤或周围环境(文章附图)。
图7 气生根粘液微生境中候选的 "保卫 "真菌抵抗环境微生物而不是固氮细菌类群
6. “保卫”真菌Chaetomella raphigera被宿主植物招募选择及其潜在的抗菌机制
为了确认“友好”“保卫”真菌C. raphigera被宿主植物蔓性野牡丹选择或招募,研究者对纯培养的C. raphigera真菌基因组和15种不同植物组织的转录组进行了测序。在真菌C. raphigera基因组共有8842个基因中,植物组织的转录本共检测到1710个基因的表达(reads FPKM>10)。有趣的是,真菌的28S rRNA基因(核糖体基因1581和1584)在不同类型的植物组织的样本转录本中广泛存在,这意味着“保卫”真菌C. raphigera可能广泛栖息在宿主植物的叶、茎、气生根和地下根中,而有无黏液和气生根该菌似乎总被宿主“招募”(图8)。
为了进一步揭示“保卫”真菌对环境微生物广谱的抗菌机制,选择农业中常见的镰刀菌(Fusarium)和稻瘟病(Magnaporthe)平板对峙进行共培养体系的转录和代谢分析。共检测到真菌C. raphigera的8080个基因表达(占基因总数的91.38%)和4723个代谢产物。此外,与单一培养的C. raphigera和病原真菌相比,LC-MS分析发现共培养过程中不同代谢产物的广泛积累,而共培养组别中C. raphigera转录组RNA-seq数据没有显著的途径差异。与猜想和之前的平板对峙共培养实验一致的是:研究者发现“保卫”真菌对病原菌形成了明显的抑菌圈,研究者因此推测真菌可能通过释放特殊的代谢产物来抑制其他病原体。共培养的转录组结果也表明,保卫真菌C. raphigera的基因表达和通路没有广泛及一致的变化,亦可以证实这一假设。因此,研究者后续重点挖掘C. raphigera中可能发挥抗菌作用的特殊代谢物,主要关注的类群是在保卫菌C. raphigera和共培养中较病原菌单培养含量更高的化合物。统计分析显示,共培养的51种代谢物与4种病原菌单独培养相比显著增加(P>0.01,图S8b),而这些代谢物在4种病原菌单独培养中未检测到或含量极低。其中,有12种代谢物(亚簇3)已被研究并显示具有广泛的抗真菌活性,如西西林、丁香酚、4-异丙基苯甲酸、肉桂醛。以上结果这些结果表明,C. raphigera代谢产物对环境真菌具有广泛的抑制作用,其广谱抗性可能是由于产生抗真菌代谢产物。除此之外,也有研究表明黏液中的固氮菌类群如克雷伯氏菌Klebsiella variicola能够降解多种毒素具有各类降解酶编码基因,保卫菌对这类细菌菌株不具有抵抗作用的原因可能是其自身具有代谢特殊真菌代谢物或毒素的功能。

图8 在植物组织中存在真菌C. raphigera (F-XTBG8)的基因及其潜在的抗真菌机制
- 结论与展望 -
植物气生根作为特殊的生态位和地上部变态根系类型,其功能往往认为与养分吸收为主的地下根系的功能有所差异。在这项研究中,研究者发现蔓性野牡丹气生根黏液富含丰富的固氮菌,其中的微生物群落能够固定大气中的氮以支持植物生长。另外,我们进一步鉴定了黏液中的一种关键的“保卫”真菌F-XTBG8具有广谱的抗菌活性,但选择性地允许固氮菌的生长。

图9 气生根黏液-功能微生物互作模型
这项研究首次发现了双子叶植物气生根-黏液通过功能微生物行使与地下根系一致的固氮的新的生物学功能,更重要的是,黏液中“友好”真菌的发现进一步加深了我们对微环境中特定功能微生物区系动态平衡机制的理解。这进一步证实了植物积极地调节植物-微生物组的相互作用,维持微生物的稳态平衡,并可能对氮素利用效率、快速生长和植物入侵产生重要影响。
此外,很有必要广泛地培养固氮和广谱抗性功能微生物,并从基因、转运蛋白和代谢基因簇等方面进一步探索这些固氮微生物和保卫真菌友好共存的分子基础。我们的研究强调了“保卫真菌”在控制气生根-黏液-固氮微环境中的关键作用,进一步研究该“友好”真菌F-XTBG8的代谢产物和广谱抗菌机制,将有助于我们破译黏液-微生物区系之间的特定相互作用和微生物动态平衡的潜在机制,对微生境功能维持和根际微生态稳态维持提供了新的见解。
参考文献
Van Deynze A, Zamora P, Delaux PM, Heitmann C, Jayaraman D, Rajasekar S, Graham D, Maeda J, Gibson D, Schwartz KD et al: Nitrogen fixation in a landrace of maize is supported by a mucilage-associated diazotrophic microbiota. PLoS Biol 2018, 16(8):e2006352.
Pang ZQ#, Mao XY#, Zhou SQ#, Yu S, Liu GZ, Lu CK, Wan JP, Hu LF*, Xu P*. 2023. Microbiota-mediated nitrogen fixation and microhabitat homeostasis in aerial root-mucilage. Microbiome
- 作者简介 -
第一作者

中国科学院
西双版纳热带植物园
庞志强
博士研究生
拟入站博士后研究人员,研究兴趣是植物-功能微生物组及其稳态维持机制,关注逆境胁迫下的植物微生物组功能与环境适应性。以第一作者发表Microbiome等期刊研究论文9篇,其中SCI收录5篇(累计被引263次,累计当年IF=41.9、入选2022 ESI 1%高被引论文1篇);中文获年度优秀论文1篇;申请专利2项,主持项目2项,担任iMeta期刊青年编委。

中国农业科学院
深圳基因组研究所
周绍群
研究员
深圳市海外高层次人才。主要研究领域为植物特异化代谢通路与调控及其在植物抗虫抗病方面的应用,重点通过跨组学数据分析阐明植物抗性相关的特异化代谢物及其遗传调控网络。以第一及通讯作者(含共同)在 Plant Cell, New Phytologist等SCI期刊上发表学术论文十余篇,累计被引700余次。
通讯作者

中国科学院
西双版纳热带植物园
徐鹏
研究员
中科院特聘核心研究员,致力于热带稻种资源利用与陆稻育种研究。针对西南山区地貌及季节性干旱突出的现状,通过热带稻资源的系统收集和挖掘,解析热带稻种耐逆、适应陆生等极端环境适应性性状的分子基础,创新陆稻分子育种技术,培育适应旱生环境下的高产优质陆稻新品种并推广应用。解析重要育种价值新基因(分子模块)6个,第一作者或者通讯作者发表SCI收录论文22篇;育成通过省级审定陆稻新品种7个,累计推广400余万亩;获云南省科技进步二等奖(排名第一)、三等奖(第一)、三农科技服务金桥奖“个人优秀奖”各1项;先后荣获云南省技术创新人才、云南省产业创新人才、云南省有突出贡献优秀专业技术人才称号;致力于热带稻种(野生稻、栽培稻地方品种)资源的收集、保护与评价利用,发掘热带稻种资源适应于极端环境的优良性状,利用分子育种开展水、陆稻的遗传改良研究。

浙江大学
胡凌飞
研究员
“百人计划”研究员,中国土壤学会土壤生态学专业委员会副主任,国家高层次青年人才项目、中国科协“青年人才托举工程”项目入选者,中国土壤学会优秀青年学者奖获得者,曾任欧洲研究理事会(ERC)项目负责人,现为国家“十四五”重点研发青年科学家项目主持人。以玉米和水稻为对象,研究植物次生代谢产物介导的植物-植食动物-微生物互作与分子机理。近年来,以第一作者或通讯作者在 Science、PNAS、Nature Communications、The Plant Cell 等权威杂志发表多篇论文,担任 Soil Ecology Letters 等期刊的青年编委。
猜你喜欢
iMeta简介 高引文章 高颜值绘图imageGP 网络分析iNAP
iMeta网页工具 代谢组MetOrigin 美吉云乳酸化预测DeepKla
iMeta综述 肠菌菌群 植物菌群 口腔菌群 蛋白质结构预测
10000+:菌群分析 宝宝与猫狗 梅毒狂想曲 提DNA发Nature
一文读懂:宏基因组 寄生虫益处 进化树 必备技能:提问 搜索 Endnote
16S功能预测 PICRUSt FAPROTAX Bugbase Tax4Fun
生物科普: 肠道细菌 人体上的生命 生命大跃进 细胞暗战 人体奥秘
写在后面
为鼓励读者交流快速解决科研困难,我们建立了“宏基因组”讨论群,己有国内外6000+ 科研人员加入。请添加主编微信meta-genomics带你入群,务必备注“姓名-单位-研究方向-职称/年级”。高级职称请注明身份,另有海内外微生物PI群供大佬合作交流。技术问题寻求帮助,首先阅读《如何优雅的提问》学习解决问题思路,仍未解决群内讨论,问题不私聊,帮助同行。
























 被折叠的 条评论
为什么被折叠?
被折叠的 条评论
为什么被折叠?








